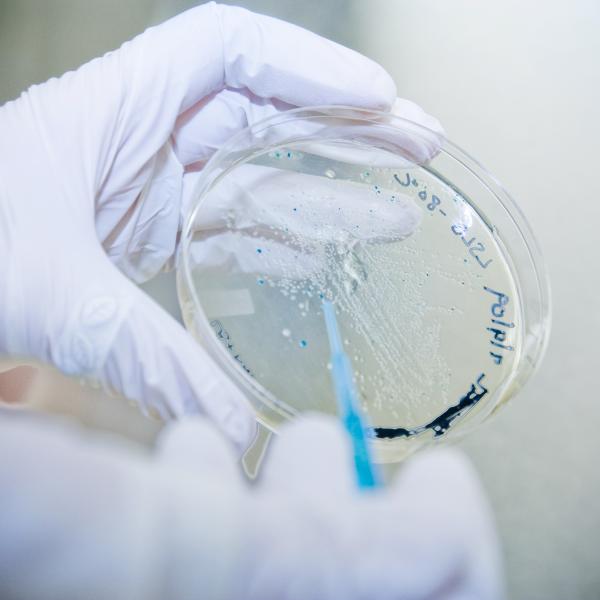
Image of biotech in petri dish.

Biotech Explorers Pathway
This two-year program explores the science of biotechnology and how discoveries move from the lab into the real world. Biotech Explorers is truly interdisciplinary, drawing on biology, chemistry, engineering, physics, computer science, management, public policy, and law. Available to first-year students only, the Biotech Explorers Pathway (BEP) introduces you to the fundamental science behind biotechnology and aims to build connections between science, business, technology, and engineering at the start of undergraduate studies; to highlight how scientific discoveries lead to useful applications; and to engage curiosity through team-based inquiry that guides students from examples toward idea generation and project development.
In addition, the first-year courses lead to second year project development and transition to fellowship experiences the summer between sophomore and junior years.
For each of the Ampersand Programs you wish to rank in your top four choices, you will need to complete a separate statement of interest (no more than 500 words) answering a program specific question. Look for the program specific questions on the program webpage.
How to Sign Up
The sign-up process with priority review for first-year programs and seminars begins on Monday, May 19, 2025, at 12 p.m. (CT). To participate in priority review, please submit your application in the first 24 hours after applications open or by Tuesday, May 20, 2025, at 12 p.m. (CT). The link to the application form will be available on the First-Year Programs homepage during that time. You will need your WashU Key to apply.